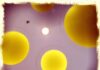
Сатурн в квадрате с Плутоном в соляре

Здравствуйте!
Вообще, Windows 10 (по умолчанию) для воспроизведения мультимедиа файлов использует приложение «Кино и ТВ» (которое не отличается «всеядностью»). И приведенная вами ошибка нередко возникает при воспроизведении некоторых файлов AVI, MP4, MKV (внутри которых могут быть использованы самые разные кодеки).
Пример ошибки на скриншоте ниже…

Ошибка Can’t Play (0xc00d36c4)
Когда нужный кодек в системе есть — видео открывается, когда нет — возникает ошибка (как на скриншоте). Впрочем, вопрос может быть связан и не только с этим…
Что делать, если появилась ошибка Can’t Play
Кто бы что не говорил, но на текущий момент, встроенные в Windows проигрыватели, существенно проигрывают сторонним продуктам (в том числе и по поддерживаемым форматам видео).
Именно поэтому, рекомендую скачать и установить 2-3 видеопроигрывателя, например, PotPlayer и VLC (Media Player Classic). Ссылка на заметку ниже.
Далее кликните правой кнопкой мышки по тому видео-файлу, который не воспроизводится, и в меню проводника выберите «Открыть с помощью -> VLC» (например).

Открыть с помощью другого проигрывателя (VLC)
Обычно, если с файлом все в порядке, VLC начнет его воспроизведение. Если «вылезет» снова ошибка — попробуйте открыть в PotPlayer (в этот проигрыватель уже встроены кодеки и он не нуждается в стороннем ПО для своей работы).
В 90% случаев сторонний проигрыватель решает проблему…
Примечание! Только не используйте в качестве проверки Windows Media (он в 10-ке тоже присутствует, и его тоже можно использовать).

Проигрывателю Windows Media не удается воспроизвести файл
Если вопрос не разрешился, то далее я бы порекомендовал установить в систему полноценный набор кодеков (K-Lite Codec Pack считается одним из лучших). В их комплекте есть все самые популярные кодеки (99%), которые только можно встретить сегодня на просторах сети.
Примечание: после установки кодеков проигрыватель (и др. программы) будет использовать их автоматически (ничего доп. настраивать не нужно).
Ссылку на статью с обзором — привожу ниже.
Как установить K-Lite Codec Pack, чтобы в системе был макс. набор кодеков — см. скриншот ниже.

Вариант установки набора кодеков MEGA pack — Lots of stuff
Обратите внимание, а загружен ли до конца ваш видеофайл (скопирован, перенесен, восстановлен и т.д.). Точно ли тот же uTorrent (например) напротив него показывает значение в 100%!
Также проверьте отзывы других людей, возможно, что раздающийся файл был битым изначально…

uTorrent — файл загружен до конца, 100%
Как вариант, можно воспользоваться видео-конвертером и перегнать плохо-воспроизводимое видео в другой формат (способ больше годится для тех случаев, когда нет возможность перезагрузить видео в другом качестве).
Сделать это достаточно просто, ниже пару ссылок в помощь.

Выбор места под новые ролики, начало конвертации / Видео-Мастер
1) Если файл воспроизводится с флешки, внутренней памяти телефона, SD-карты и т.д.
В этом случае попробуйте его сначала скопировать на жесткий диск компьютера, а после открыть в видео-проигрывателе. Нередко, с внутренней памяти телефона (например) не удается воспроизвести не только видео, но и просмотреть фото…
2) Если файл был восстановлен после удаления или форматирования с помощью спец. программ
Нередко в этом случае файлы не открываются, т.к. частично были повреждены. Но кое что в этом случае сделать можно ->
3) Если видеофайл был получен с регистратора или камеры наблюдения
В этом случае файл может быть зашифрованным — т.е. его не получится открыть без спец. кодека (дешифратора). Обычно, для решения подобной загвоздки — нужно зайти на сайт производителя вашего регистратора (например), и загрузить специализированное ПО.
Более подробно об этом здесь: https://ocomp.info/kak-otkryit-fayl-s-videoregistratora.html
4) Не заражена ли система вирусным (рекламным) ПО
Невозможность просматривать видео (иногда появление баннеров и рекламных предложений вначале видео, или вместо него) указывает на заражение вашей системы вирусами. Рекомендую установить один из современных антивирусов, и проверить полностью систему (пару ссылок ниже в помощь).